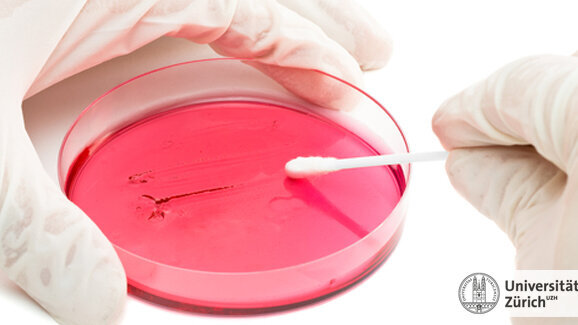
Versteckte Bakterien aufspüren

ZÜRICH - Die Bakterienkultur, die bisher als beste Methode für den Nachweis einer bakteriellen Infektion galt, versagt offenbar in vielen Fällen. Eine Genanalyse könnte Abhilfe schaffen, hat UZH-Mediziner Guido Bloemberg herausgefunden.
Bisher galt das Anlegen einer Bakterienkultur als einfachste Methode, um eine bakterielle Infektion nachzuweisen. Was aber tun, wenn in der Kultur keine Bakterien wachsen, der Patient jedoch ganz offensichtlich an einer bakteriellen Infektion leidet? Eine Genanalyse kann in diesen Fällen helfen, hat UZH-Mediziner Guido Bloemberg herausgefunden.
Schon manch ein Arzt sah sich mit folgender Situation konfrontiert: Der Patient weist Symptome einer bakteriellen Infektion auf, die angelegte Bakterienkultur ist jedoch negativ, das heisst, von der entnommenen Probe lassen sich keine krankmachenden Bakterien im Nährmedium vermehren. Was tun? Ohne den genauen Erreger zu kennen, verschreibt der Arzt ein Breitband-Antibiotikum in der Hoffnung, dieses wirke auch gegen das vermutete Bakterium. Oft geht dies gut, doch die Sache hat Nachteile.
Da der Arzt den genauen Erreger nicht kennt, wählt er unter Umständen nicht das genau passende Antibiotikum oder wendet es nicht genügend lange an, so dass der Patient nicht richtig gesund wird. Die Bakterienkultur, die bisher als beste Methode für den Nachweis einer bakteriellen Infektion galt, versagt offenbar in vielen Fällen. Seit einigen Jahren steht ein anderes Instrument zur Verfügung, um eine bakterielle Infektion zu diagnostizieren: die «16S rRNA Gen PCR Analyse».
Klinisch relevant
Guido Bloemberg, Leiter der Molekularen Diagnostik am Institut für Medizinische Mikrobiologie der Universität Zürich, hat die Tauglichkeit dieser Methode mit derjenigen der Bakterienkultur verglichen. Gleichzeitig hat er zeigen können, dass die 16S rRNA Gen PCR Analyse in den Fällen einer negativen Bakterienkultur zusätzliche Informationen über die Infektion des Patienten liefern kann. Die Resultate seiner Studie sind für die Arbeit in der Klinik bedeutsam und wurden in der Fachzeitschrift «Clinical Infectious Diseases» veröffentlicht.
Lesen Sie hier den vollständigen Artikel.
Bern – Die Entdeckung der Antibiotika im 20. Jahrhundert bedeutete für die Medizin eine Revolution und hat unzähligen Menschen das Leben gerettet. Doch ...
STUTTGART – Bakterien haften besonders gut durch die Ausscheidung von Polymeren, wie eine Untersuchung der Universität Stuttgart belegt.
St. Gallen – Eine neuartige, lichtaktivierbare Kunststoffbeschichtung der Empa-Forschenden soll künftig helfen, antibiotikaresistente Keime gezielt zu ...
KARLSRUHE – Gefäßerweiternde Stents, „Labs-on-Chip“ für Analysen auf kleinster Fläche, 3-D-Zellkultursysteme für die Geweberekonstruktion: ...
HEIDElBERG - Bestimmte Bakterien können mit Hilfe einer molekularen Tarnkappe Abwehrreaktionen des Immunsystems verhindern, wie Wissenschaftler jetzt ...
HANNOVER – Wissenschaftlerinnen und Wissenschaftler der MHH und der Universität von Jerusalem: Bakterien und Immunzellen im Zahnfleisch halten sich ...
CONNECTICUT, USA – Herzinfarkte und Schlaganfälle haben meistens ihre Ursache in Arteriosklerose.
PHILADELPHIA, USA – Eine neue Studie der University of Pennsylvania zeigt, wie Parodontitis-Bakterien auf das Immunsystem einwirken, um ihre ...
NEW JERSEY - Das Anbringen von Graphen-basierten Nanosensoren auf Zahnschmelz könnte die Überwachung des Gesundheitszustandes einschlägig ...
ZÜRICH/LEIPZIG – Wird ein Implantat gesetzt, kommt es bei jedem zehnten Patienten zu Komplikationen wie etwa Periimplantitis. Züricher ...
Live-Webinar
Di. 23. Juni 2026
2:00 Uhr (CET) Zurich
Live-Webinar
Di. 23. Juni 2026
19:00 Uhr (CET) Zurich
Live-Webinar
Di. 23. Juni 2026
21:00 Uhr (CET) Zurich
Live-Webinar
Mi. 24. Juni 2026
14:00 Uhr (CET) Zurich
Live-Webinar
Mi. 24. Juni 2026
17:00 Uhr (CET) Zurich
Live-Webinar
Mi. 24. Juni 2026
18:30 Uhr (CET) Zurich
Dr. med. dent. Britta Hahn
Live-Webinar
Do. 25. Juni 2026
20:00 Uhr (CET) Zurich
Dr. Hatem Algraffee, Cat Edney



 Österreich / Österreich
Österreich / Österreich
 Bosnien und Herzegowina / Босна и Херцеговина
Bosnien und Herzegowina / Босна и Херцеговина
 Bulgarien / България
Bulgarien / България
 Kroatien / Hrvatska
Kroatien / Hrvatska
 Tschechien & Slowakei / Česká republika & Slovensko
Tschechien & Slowakei / Česká republika & Slovensko
 Frankreich / France
Frankreich / France
 Deutschland / Deutschland
Deutschland / Deutschland
 Griechenland / ΕΛΛΑΔΑ
Griechenland / ΕΛΛΑΔΑ
 Ungarn / Hungary
Ungarn / Hungary
 Italien / Italia
Italien / Italia
 Niederlande / Nederland
Niederlande / Nederland
 Nordic / Nordic
Nordic / Nordic
 Polen / Polska
Polen / Polska
 Portugal / Portugal
Portugal / Portugal
 Rumänien & Moldawien / România & Moldova
Rumänien & Moldawien / România & Moldova
 Slowenien / Slovenija
Slowenien / Slovenija
 Serbien & Montenegro / Србија и Црна Гора
Serbien & Montenegro / Србија и Црна Гора
 Spanien / España
Spanien / España
 Schweiz / Schweiz
Schweiz / Schweiz
 Türkei / Türkiye
Türkei / Türkiye
 Großbritannien und Irland / UK & Ireland
Großbritannien und Irland / UK & Ireland
 International / International
International / International
 Brasilien / Brasil
Brasilien / Brasil
 Kanada / Canada
Kanada / Canada
 Lateinamerika / Latinoamérica
Lateinamerika / Latinoamérica
 USA / USA
USA / USA
 China / 中国
China / 中国
 Indien / भारत गणराज्य
Indien / भारत गणराज्य
 Pakistan / Pākistān
Pakistan / Pākistān
 Vietnam / Việt Nam
Vietnam / Việt Nam
 ASEAN / ASEAN
ASEAN / ASEAN
 Israel / מְדִינַת יִשְׂרָאֵל
Israel / מְדִינַת יִשְׂרָאֵל
 Algerien, Marokko und Tunesien / الجزائر والمغرب وتونس
Algerien, Marokko und Tunesien / الجزائر والمغرب وتونس
 Naher Osten / Middle East
Naher Osten / Middle East

To post a reply please login or register